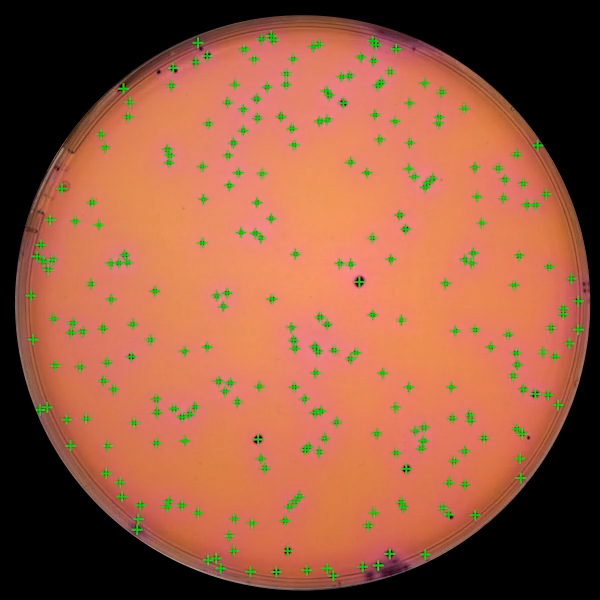

Obtenga resultado anticipados
Siga el crecimiento bacteriano de sus análisis en tiempo real.
Gracias a la tecnología ScanStation, las colonias se detectan y se cuentan desde su aparación, reduciendo significativamente el tiempo de obtención de los resultados: hasta tres veces más rápido que el método tradicional.
Siga el crecimiento bacteriano con el recuento en tiempo real
Obtenga resultados hasta 3 veces más rápido y optimice su proceso
Una solución innovadora para una mejor gestión de su producción
Automatización en laboratorio, un desafío importante
Combine la metodología tradicional con métodos rápidos y sus resultados anticipados, manteniendo costos operativos ventajosos. Adopte el sistema de monitoreo en tiempo real para ayudar en la detección rápida de posibles contaminantes y reducir el riesgo del producto según el Anexo 1 de las GMP.
Carga de hasta 300 placas de Petri
Funcionamiento 24/7
horas del día
Carga por lotes o continua
Carga por lotes o continua
Comprobación visual
del análisis en curso
Mejora de la calidad de sus resultados eliminando los errores manuales
Estandarización de los procedimientos
Cumplimiento de las normas regulatorias (GMP, AOAC, ISO)
Mantenga sus proveedores actuales de placas de Petri, equipos y consumibles asociados ya validados
Nuestro sistema de automatización está diseñado para adaptarse a su proceso existente. Analice todo tipo de medios de cultivo en placas de 55-90 mm (superficie, profundidad, espiral), membranas de filtración, contact plate.




PDA
TSA/PCA
MRS
VRBL / VRBG




TBX
SLANETZ
SABOURAUD
R2A




YEAST AND MOLD AGAR
GVPC
TTC
BAIRD PARKER / RPF

Nuestros expertos técnicos y aplicativos están a su disposición para ayudarle
Desde la instalación hasta la cualificación IQOQ, le garantizamos una rápida implantación en sus instalaciones. Nuestros expertos en aplicaciones están a su disposición para ayudarle a integrar el ScanStation a su protocolo analítico.